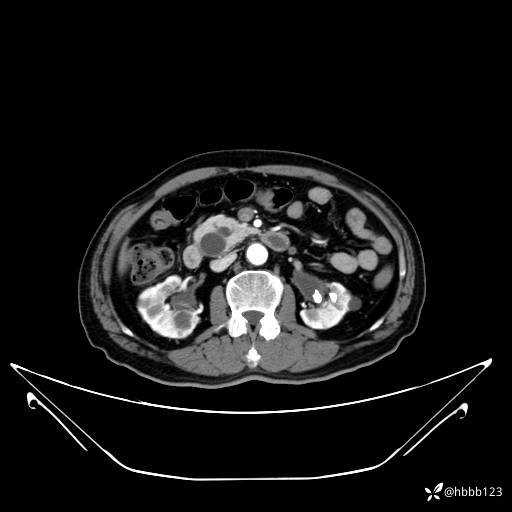
img
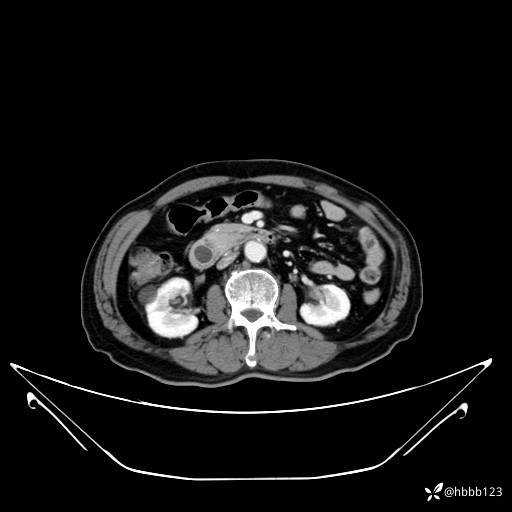
img
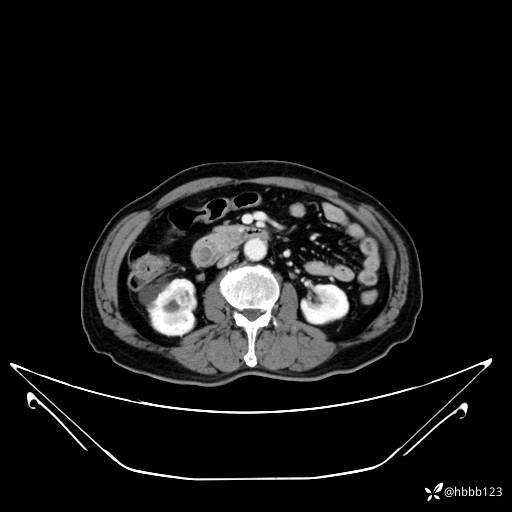
img

【腹部】68岁男性巩膜黄染,CT发现占位,请您诊断。(有结果)
病例信息
患者男,68岁。
主要病史:患者自诉1月前无明显诱因出现皮肤巩膜黄染,现为进一步诊治,来我科就诊。
既往:“2型糖尿病”25年余。
诊断:1.2型糖尿病。2.巩膜黄染。
门诊完善上腹部CT平扫+增强扫描:
动脉期:











门脉期:











延迟期:










平扫:







病例信息
患者男,68岁。
主要病史:患者自诉1月前无明显诱因出现皮肤巩膜黄染,现为进一步诊治,来我科就诊。
既往:“2型糖尿病”25年余。
诊断:1.2型糖尿病。2.巩膜黄染。
门诊完善上腹部CT平扫+增强扫描:
动脉期:

门脉期:

延迟期:

平扫:







